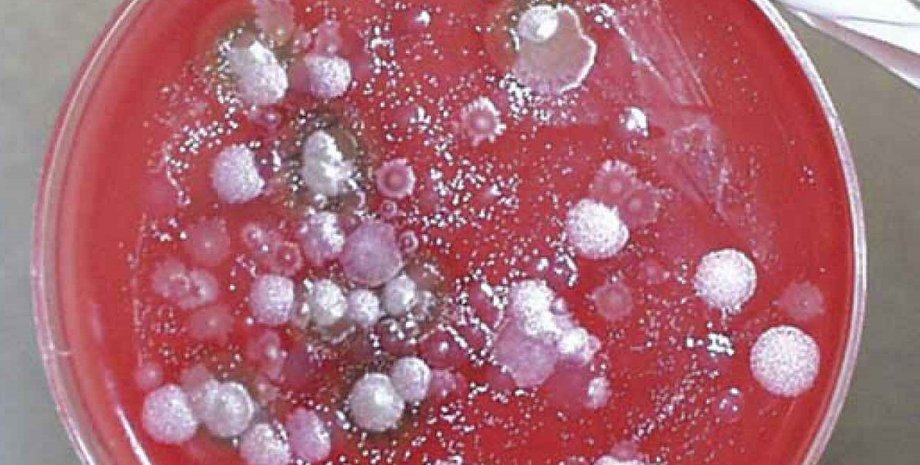
Споры сибирской язвы / Фото: imgkid.com

Мир

Споры сибирской язвы / Фото: imgkid.com
Американские военные случайно разослали споры сибирской язвы
Материал необходим был для исследований, но споры не должны были быть живыми
Американские военные по ошибке направили образцы живых спор сибирской язвы в девять лабораторий США, а также в Южную Корею, сообщает BBC.
Четверо сотрудников лаборатории в штате Мэриленд находятся на обследовании и принимают необходимые препараты.
В Пентагоне подчеркнули, что споры сибирской язвы необходимы были для экспериментов, но они не должны были быть живыми. В связи с инцидентом проводится расследование.
Напомним, в 2012 году в торговую сеть Мелитопольского района (Запорожсая обл.) попало мясо коровы, погибшей от сибирской язвы.
Відео дня
